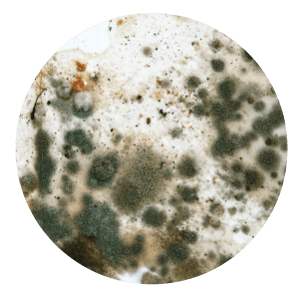

EN What is Active Oxygen?
Active Oxygen is nature’s natural air cleaner. Nature creates Active Oxygen to clean the environment through
What is Active Oxygen?
Active Oxygen is nature’s natural air cleaner. Nature creates Active Oxygen to clean the environment through

Break Free From
Sinus allergies
Viruses & Bacteria
Cross infections
Bad smells
The haze
Hand Foot & Mouth Disease (HFMD)
Do Something
About Your Sinus Allergies
Why are you or a loved one putting up with feeling congested all the time when there is a simple and natural solution?
Eliminate Viruses & Bacteria
Why are you putting up with loved ones getting infected and spreading the infections when there is a simple and natural solution?
Do Something
Reduce Cross Infections
Why are you putting up with loved ones getting infected and spreading the infections when there is a simple and natural solution?
Do Something
About The Bad Smells In Your Life
Why are you putting up with bad smells in the environments in which you live, when there is a simple and natural solution?
Do Something
About The Haze
Why are you putting up with the hazy days when there is a simple and natural solution?
Do Something
Hand Foot And Mouth Disease (HFMD)
The real cost of hand foot and mouth disease (HFMD)
Versa 45s
Enjoy cleaner air and surfaces, in style, wherever you go. Providing protection for you and your loved ones 24/7
Click here to view in your space
Coverage Area
450 sq ft
Add on colour casing option (RM99/casing)
Original Colour: Metallic Silver
Selected Colour: Metallic Silver
Selected Colour: Classic Titanium
Selected Colour: Rose Gold
Selected Colour: Pearl White
Selected Colour: Sunshine Yellow
Selected Colour: Sexy Red
Selected Colour: Pastel Pink
Selected Colour: Happy Green
Selected Colour: Calm Blue
Autoplus
Sterilizing your air and surfaces in your car, providing protection for you and your loved ones while on the move.
Click here to view in your space
Suitable for
Vehicles using 12V car battery
Selected Colour: Classic Titanium
Selected Colour: Blue
Selected Colour: Pink
Our Clients